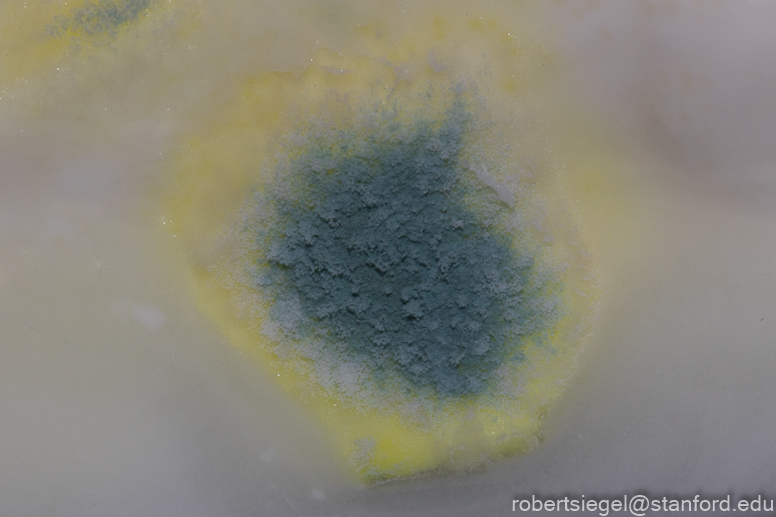
my house 2021

Food
Food
 Birds
Birds
 Flora
Flora
 Aquarium
Aquarium
 Bugs
Bugs
 Fungi
Fungi
 Food
Food
 Birds
Birds
 Flora
Flora
 Aquarium
Aquarium
 Bugs
Bugs
 Fungi
Fungi

My Yard 2021
My Yard 2021
 My Yard 2020
My Yard 2020
 My Yard
My Yard
 My House
My House
 My House 2017
My House 2017
 My House 2019
My House 2019
 My House 2020
My House 2020
 My House 2021
My House 2021
 My House 2022
My House 2022
 Arcadia Place
Arcadia Place
 Breakfast club
Breakfast club
 Breakfast Club 2021
Breakfast Club 2021
 Eleanor Pardee Park
Eleanor Pardee Park
 Palo Alto
Palo Alto


Last modified: January 14, 2022
Created: January 10, 2022 (from myhouse2021.html)
Contact: siegelr@stanford.edu
All pictures are protected by copyright. Do not use without permission.